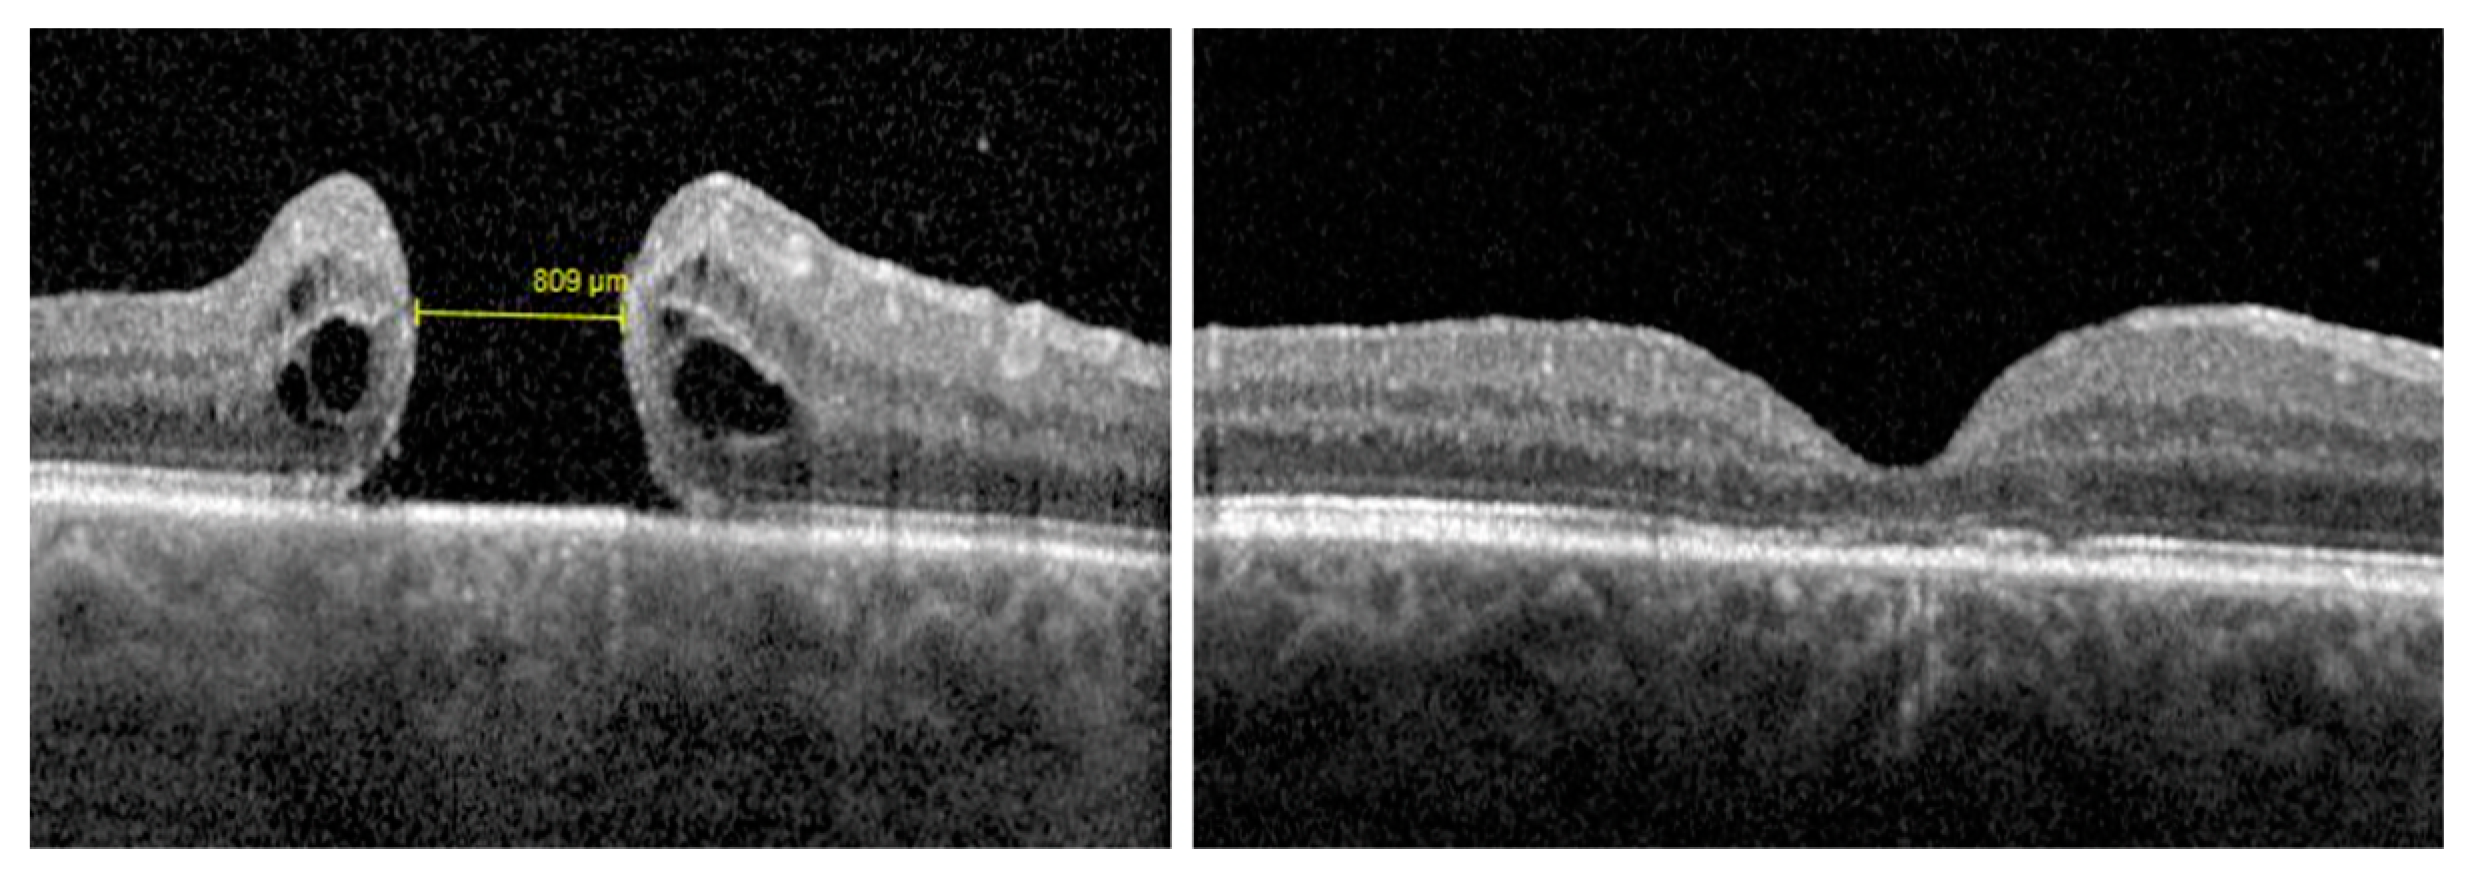
Jcm 12 02050 g002

The Short-Term Results of Autologous Platelet-Rich Plasma as an Adjuvant to Re-Intervention in the Treatment of Refractory Full-Thickness Macular Holes
Abstract
1. Introduction
2. Materials and Methods
2.1. Inclusion and Exclusion Criteria
- -
- A previous PPV with ILM peeling and gas tamponade due to an idiopathic FTMH or myopic FTMH or optic disc pit maculopathy (ODPM), and
- -
- adult patients (age > 18 years), and
- -
- rFTMHs associated with high myopia (defined as eyes with an axial length greater than 26.5 mm or a refractive error greater than -6D or both), or
- -
- large rFTMHs (minimum hole width > 400 μm, according to the (OCT)-based International Vitreomacular Traction Study Group (IVTS) classification [21]), or
- -
- rFTMHs associated with ODPM.
2.2. Surgical Procedure
2.3. Ophthalmic Evaluation
2.4. Statistical Analysis
3. Results
4. Discussion
Author Contributions
Funding
Institutional Review Board Statement
Informed Consent Statement
Data Availability Statement
Conflicts of Interest
References
- Abdelkader, E.; Lois, N. Internal Limiting Membrane Peeling in Vitreo-Retinal Surgery. Surv. Ophthalmol. 2008, 53, 368–396. [Google Scholar] [CrossRef] [PubMed]
- Ch’ng, S.W.; Patton, N.; Ahmed, M.; Ivanova, T.; Baumann, C.; Charles, S.; Jalil, A. The Manchester Large Macular Hole Study: Is It Time to Reclassify Large Macular Holes? Am. J. Ophthalmol. 2018, 195, 36–42. [Google Scholar] [CrossRef]
- Chatziralli, I.; Machairoudia, G.; Kazantzis, D.; Theodossiadis, G.; Theodossiadis, P. Inverted Internal Limiting Membrane Flap Technique for Myopic Macular Hole: A Meta-Analysis. Surv. Ophthalmol. 2021, 66, 771–780. [Google Scholar] [CrossRef] [PubMed]
- Chen, G.; Tzekov, R.; Jiang, F.; Mao, S.; Tong, Y.; Li, W. Inverted ILM Flap Technique versus Conventional ILM Peeling for Idiopathic Large Macular Holes: A Meta-Analysis of Randomized Controlled Trials. PLoS ONE 2020, 15, e0236431. [Google Scholar] [CrossRef]
- Romano, M.R.; Rossi, T. Review Article Management of Refractory and Recurrent Macular Holes: A Comprehensive Review. Surv. Ophthalmol. 2022, 67, 908–931. [Google Scholar] [CrossRef] [PubMed]
- Tam, A.L.C.; Yan, P.; Gan, N.Y.; Lam, W.C. The Current Surgical Management of Large, Recurrent, or Persistent Macular Holes. Retina 2018, 38, 1263–1275. [Google Scholar] [CrossRef] [PubMed]
- Shpak, A.A.; Shkvorchenko, D.O.; Krupina, E.A. Surgical Treatment of Macular Holes with and without the Use of Autologous Platelet-Rich Plasma. Int. Ophthalmol. 2021, 41, 1043–1052. [Google Scholar] [CrossRef]
- Figueroa, M.S.; Govetto, A.; Arriba-Palomero, P. de Short-Term Results of Platelet-Rich Plasma as Adjuvant to 23-G Vitrectomy in the Treatment of High Myopic Macular Holes. Eur. J. Ophthalmol. 2015, 26, 491–496. [Google Scholar] [CrossRef]
- Cheung, C.M.G.; Munshi, V.; Mughal, S.; Mann, J.; Hero, M. Anatomical Success Rate of Macular Hole Surgery with Autologous Platelet without Internal-Limiting Membrane Peeling. Eye 2005, 19, 1191–1193. [Google Scholar] [CrossRef]
- Purtskhvanidze, K.; Frühsorger, B.; Bartsch, S.; Hedderich, J.; Roider, J.; Treumer, F. Persistent Full-Thickness Idiopathic Macular Hole: Anatomical and Functional Outcome of Revitrectomy with Autologous Platelet Concentrate or Autologous Whole Blood. Ophthalmologica 2017, 239, 19–26. [Google Scholar] [CrossRef]
- Degenhardt, V.; Busch, C.; Jochmann, C.; Meier, P.; Unterlauft, J.D.; Mößner, A.; Edel, E.; Tewari, R.; Wiedemann, P.; Rehak, M. Prognostic Factors in Patients with Persistent Full-Thickness Idiopathic Macular Holes Treated with Re-Vitrectomy with Autologous Platelet Concentrate. Ophthalmologica 2019, 242, 214–221. [Google Scholar] [CrossRef]
- Alves, R.; Grimalt, R. A Review of Platelet-Rich Plasma: History, Biology, Mechanism of Action, and Classification. Skin Appendage Disord. 2018, 4, 18–24. [Google Scholar] [CrossRef]
- Campochiaro, P.A.; Hackett, S.F.; Vinores, S.A.; Freund, J.; Csaky, C.; LaRochelle, W.; Henderer, J.; Johnson, M.; Rodriguez, I.R.; Friedman, Z.; et al. Platelet-Derived Growth Factor Is an Autocrine Growth Stimulator in Retinal Pigmented Epithelial Cells. J. Cell Sci. 1994, 107, 2459–2469. [Google Scholar] [CrossRef] [PubMed]
- Zheng, C.; Zhu, Q.; Liu, X.; Huang, X.; He, C.; Jiang, L.; Quan, D.; Zhou, X.; Zhu, Z. Effect of Platelet-Rich Plasma (PRP) Concentration on Proliferation, Neurotrophic Function and Migration of Schwann Cells in Vitro. J. Tissue Eng. Regen Med. 2016, 10, 428–436. [Google Scholar] [CrossRef] [PubMed]
- Burmeister, S.L.; Hartwig, D.; Astrid Limb, G.; Kremling, C.; Hoerauf, H.; Müller, M.; Geerling, G. Effect of Various Platelet Preparations on Retinal Müller Cells. Investig. Ophthalmol. Vis. Sci. 2009, 50, 4881–4886. [Google Scholar] [CrossRef]
- Castelnovo, L.; Dosquet, C.; Gaudric, A.; Sahel, J.; Hicks, D. Human Platelet Suspension Stimulates Porcine Retinal Glial Proliferation and Migration in Vitro. Investig. Ophthalmol. Vis. Sci. 2000, 41, 601–609. [Google Scholar]
- Wu, A.L.; Liu, Y.T.; da Chou, H.; Chuang, L.H.; Chen, K.J.; Chen, Y.P.; Liu, L.; Yeung, L.; Wang, N.K.; Hwang, Y.S.; et al. Role of Growth Factors and Internal Limiting Membrane Constituents in Müller Cell Migration. Exp. Eye Res. 2021, 202, 108352. [Google Scholar] [CrossRef] [PubMed]
- Velhagen, K.H.; Druegg, A.; Rieck, P. Proliferation and Wound Healing of Retinal Pigment Epithelium Cells in Vitro. Effect of Human Thrombocyte Concentrate, Serum and PDGF. Ophthalmologe 1999, 96, 77–81. [Google Scholar] [CrossRef]
- Figueroa, M.S.; Mora Cantallops, A.; Virgili, G.; Govetto, A. Long-Term Results of Autologous Plasma as Adjuvant to Pars Plana Vitrectomy in the Treatment of High Myopic Full-Thickness Macular Holes. Eur. J. Ophthalmol. 2021, 31, 2612–2620. [Google Scholar] [CrossRef]
- D’Alterio, F.M.; Ferrara, M.; Bagnall, A.; Talks, K.L.; Hillier, R.J. Platelet-Rich Plasma and Macular Hole Surgery: A Clue to Their Mode of Action and the Influence of Anti-Platelet Agents. Eur. J. Ophthalmol. 2022, 112067212210936. [Google Scholar] [CrossRef] [PubMed]
- Duker, J.S.; Kaiser, P.K.; Binder, S.; de Smet, M.D.; Gaudric, A.; Reichel, E.; Sadda, S.R.; Sebag, J.; Spaide, R.F.; Stalmans, P. The International Vitreomacular Traction Study Group Classification of Vitreomacular Adhesion, Traction, and Macular Hole. Ophthalmology 2013, 120, 2611–2619. [Google Scholar] [CrossRef] [PubMed]
- Rossi, T.; Bacherini, D.; Caporossi, T.; Telani, S.; Iannetta, D.; Rizzo, S.; Moysidis, S.N.; Koulisis, N.; Mahmoud, T.H.; Ripandelli, G. Macular Hole Closure Patterns: An Updated Classification. Graefe’s Arch. Clin. Exp. Ophthalmol. 2020, 258, 2629–2638. [Google Scholar] [CrossRef]
- Ferrara, M.; Mehta, A.; Qureshi, H.; Avery, P.; Yorston, D.; Laidlaw, D.A.; Williamson, T.H.; Steel, D.H.W.; Casswell, A.G.; Morris, A.H.C.; et al. Phenotype and Outcomes of Phakic Versus Pseudophakic Primary Rhegmatogenous Retinal Detachments: Cataract or Cataract Surgery Related? Am. J. Ophthalmol. 2021, 222, 318–327. [Google Scholar] [CrossRef]
- Marques, R.E.; Sousa, D.C.; Leal, I.; Faria, M.Y.; Marques-Neves, C. Complete ILM Peeling versus Inverted Flap Technique for Macular Hole Surgery: A Meta-Analysis. Ophthalmic. Surg. Lasers Imaging Retin. 2020, 51, 187-A2. [Google Scholar] [CrossRef] [PubMed]
- Hillenkamp, J.; Kraus, J.; Framme, C.; Jackson, T.L.; Roider, J.; Gabel, V.P.; Sachs, H.G. Retreatment of Full-Thickness Macular Hole: Predictive Value of Optical Coherence Tomography. Br. J. Ophthalmol. 2007, 91, 1445–1449. [Google Scholar] [CrossRef] [PubMed]
- Babu, N.; Kohli, P.; Ramasamy, K. Comparison of Various Surgical Techniques for Optic Disc Pit Maculopathy: Vitrectomy with Internal Limiting Membrane (ILM) Peeling Alone versus Inverted ILM Flap “plug” versus Autologous Scleral “Plug”. Br. J. Ophthalmol. 2020, 104, 1567–1573. [Google Scholar] [CrossRef] [PubMed]
- Anitua, E.; de la Sen-Corcuera, B.; Orive, G.; Sánchez-Ávila, R.M.; Heredia, P.; Muruzabal, F.; Merayo-Lloves, J. Progress in the Use of Plasma Rich in Growth Factors in Ophthalmology: From Ocular Surface to Ocular Fundus. Expert. Opin. Biol. Ther. 2022, 22, 31–45. [Google Scholar] [CrossRef] [PubMed]
- Kim, M.; Won, J.Y.; Choi, S.Y.; Kim, M.; Ra, H.; Jee, D.; Kwon, J.W.; Kang, K.D.; Roh, Y.J.; Park, Y.G.; et al. Therapeutic Efficacy of Autologous Platelet Concentrate Injection on Macular Holes with High Myopia, Large Macular Holes, or Recurrent Macular Holes: A Multicenter Randomized Controlled Trial. J. Clin. Med. 2021, 10, 2727. [Google Scholar] [CrossRef] [PubMed]
- Rangel, C.M.; Blanco, N.A.; Pedraza-Concha, A.; Gomez, M.A.; Parra, M.M.; Arias, J.D. Plasma Rich in Growth Factors as Treatment for a Full-Thickness Macular Hole Due to Macular Telangiectasia Type 2. Arch. Soc. Esp. Oftalmol. 2022, 97, 219–223. [Google Scholar] [CrossRef]
- Hagenau, F.; Luft, N.; Nobl, M.; Vogt, D.; Klaas, J.E.; Schworm, B.; Siedlecki, J.; Kreutzer, T.C.; Priglinger, S.G. Improving Morphological Outcome in Lamellar Macular Hole Surgery by Using Highly Concentrated Autologous Platelet-Rich Plasma. Graefe’s Arch. Clin. Exp. Ophthalmol. 2022, 260, 1517–1524. [Google Scholar] [CrossRef]
- Dimopoulos, S.; William, A.; Voykov, B.; Ziemssen, F.; Bartz-Schmidt, K.U.; Spitzer, M.S. Anatomical and Visual Outcomes of Autologous Thrombocyte Serum Concentrate in the Treatment of Persistent Full-Thickness Idiopathic Macular Hole after ILM Peeling with Brilliant Blue G and Membrane Blue Dual. Acta Ophthalmol. 2017, 95, e429–e430. [Google Scholar] [CrossRef]
- Valldeperas, X.; Wong, D. Is It Worth Reoperating on Macular Holes? Ophthalmology 2008, 115, 158–163. [Google Scholar] [CrossRef]
- Bodhankar, P.; Joshi, A.; Dronadula, M.; Patil, A. Postoperative Microstructural Re-Modelling and Functional Outcomes in Idiopathic Full Thickness Macular Hole. Indian J. Ophthalmol. 2022, 70, 2077. [Google Scholar] [CrossRef] [PubMed]
- Bleidißel, N.; Friedrich, J.; Feucht, N.; Klaas, J.; Maier, M. Visual Improvement and Regeneration of Retinal Layers in Eyes with Small, Medium, and Large Idiopathic Full-Thickness Macular Holes Treated with the Inverted Internal Limiting Membrane Flap Technique over a Period of 12 Months. Graefe’s Arch. Clin. Exp. Ophthalmol. 2022, 260, 3161–3171. [Google Scholar] [CrossRef] [PubMed]
- Oh, J.; Yang, S.M.; Choi, Y.M.; Kim, S.W.; Huh, K. Glial Proliferation after Vitrectomy for a Macular Hole: A Spectral Domain Optical Coherence Tomography Study. Graefe’s Arch. Clin. Exp. Ophthalmol. 2013, 251, 477–484. [Google Scholar] [CrossRef] [PubMed]
- Salem, N.A.; Hamza, A.; Alnahdi, H.; Ayaz, N. Biochemical and Molecular Mechanisms of Platelet-Rich Plasma in Ameliorating Liver Fibrosis Induced by Dimethylnitrosurea. Cell. Physiol. Biochem. 2018, 47, 2331–2339. [Google Scholar] [CrossRef]
- Maguire, M.J.; Steel, D.H.; Yorston, D.; Hind, J.; El-Faouri, M.; Jalil, A.; Tyagi, P.; Wickham, L.; Laidlaw, A.H. Outcome of Revision Procedures for Failed Primary Macular Hole Surgery. Retina 2021, 41, 1389–1395. [Google Scholar] [CrossRef]
- Frisina, R.; Gius, I.; Tozzi, L.; Midena, E. Refractory Full Thickness Macular Hole: Current Surgical Management. Eye 2022, 36, 1344–1354. [Google Scholar] [CrossRef]
- Gamulescu, M.A.; Roider, J.; Gabel, V.P. Exudative Retinal Detachment in Macular Hole Surgery Using Platelet Concentrates—A Case Report. Graefe’s Arch. Clin. Exp. Ophthalmol. 2001, 239, 227–229. [Google Scholar] [CrossRef]
- Schaub, F.; Gözlügöl, N.; von Goscinski, C.; Enders, P.; Heindl, L.M.; Dahlke, C. Outcome of Autologous Platelet Concentrate and Gas Tamponade Compared to Heavy Silicone Oil Tamponade in Persistent Macular Hole Surgery. Eur. J. Ophthalmol. 2021, 31, 664–672. [Google Scholar] [CrossRef]

| Overall | HM Group | L Group | ODPM Group | |
|---|---|---|---|---|
| Age (mean, years) | 61 ± 8.78 | 62.1 ± 6.6 | 65 ± 6.3 | 46 ± 4.5 |
| Sex (% male) | 42.8% | 33.3% | 41.7% | 75% |
| Laterality (% right) | 53.6% | 66.7% | 50% | 25% |
| Overall | Highly Myopic rFTMHs | Large rFTMHs | rFTMHs Associated with ODPM | |
|---|---|---|---|---|
| Closure rate | 26/28 (92.9%) | 11/12 (91.7%) | 11/12 (91.7%) | 4/4 (100%) |
| Closure type 1A | 13/28 (46.4%) | 5/12 (41.7%) | 5/12 (41.7%) | 3/4 (75.0%) |
| Closure type 1B | 2/28 (7.1%) | 1/12 (8.3%) | 0/12 (0%) | 1/4 (25.0%) |
| Closure type 1C | 11/28 (39.3%) | 5/12 (41.7%) | 6/12 (50.0%) | 0/4 (0%) |
| Residual ELM defect | 8/28 (25.6%) | 6/12 (50.0%) | 4/12 (33.3%) | 1/4 (25%) |
| Residual EZ defect | 21/28 (75.0%) | 8/12 (66.7%) | 11/12 (91.7%) | 2/4 (50%) |
| Fibrin-like HR tissue | 1/28 (3.6%) | 1/12 (8.3%) | 0/12 (0%) | 0/4 (0%) |
Disclaimer/Publisher’s Note: The statements, opinions and data contained in all publications are solely those of the individual author(s) and contributor(s) and not of MDPI and/or the editor(s). MDPI and/or the editor(s) disclaim responsibility for any injury to people or property resulting from any ideas, methods, instructions or products referred to in the content. |
© 2023 by the authors. Licensee MDPI, Basel, Switzerland. This article is an open access article distributed under the terms and conditions of the Creative Commons Attribution (CC BY) license (https://creativecommons.org/licenses/by/4.0/).
Share and Cite
Buzzi, M.; Parisi, G.; Marolo, P.; Gelormini, F.; Ferrara, M.; Raimondi, R.; Allegrini, D.; Rossi, T.; Reibaldi, M.; Romano, M.R. The Short-Term Results of Autologous Platelet-Rich Plasma as an Adjuvant to Re-Intervention in the Treatment of Refractory Full-Thickness Macular Holes. J. Clin. Med. 2023, 12, 2050. https://doi.org/10.3390/jcm12052050
Buzzi M, Parisi G, Marolo P, Gelormini F, Ferrara M, Raimondi R, Allegrini D, Rossi T, Reibaldi M, Romano MR. The Short-Term Results of Autologous Platelet-Rich Plasma as an Adjuvant to Re-Intervention in the Treatment of Refractory Full-Thickness Macular Holes. Journal of Clinical Medicine. 2023; 12(5):2050. https://doi.org/10.3390/jcm12052050
Chicago/Turabian StyleBuzzi, Matilde, Guglielmo Parisi, Paola Marolo, Francesco Gelormini, Mariantonia Ferrara, Raffaele Raimondi, Davide Allegrini, Tommaso Rossi, Michele Reibaldi, and Mario R. Romano. 2023. "The Short-Term Results of Autologous Platelet-Rich Plasma as an Adjuvant to Re-Intervention in the Treatment of Refractory Full-Thickness Macular Holes" Journal of Clinical Medicine 12, no. 5: 2050. https://doi.org/10.3390/jcm12052050
APA StyleBuzzi, M., Parisi, G., Marolo, P., Gelormini, F., Ferrara, M., Raimondi, R., Allegrini, D., Rossi, T., Reibaldi, M., & Romano, M. R. (2023). The Short-Term Results of Autologous Platelet-Rich Plasma as an Adjuvant to Re-Intervention in the Treatment of Refractory Full-Thickness Macular Holes. Journal of Clinical Medicine, 12(5), 2050. https://doi.org/10.3390/jcm12052050

